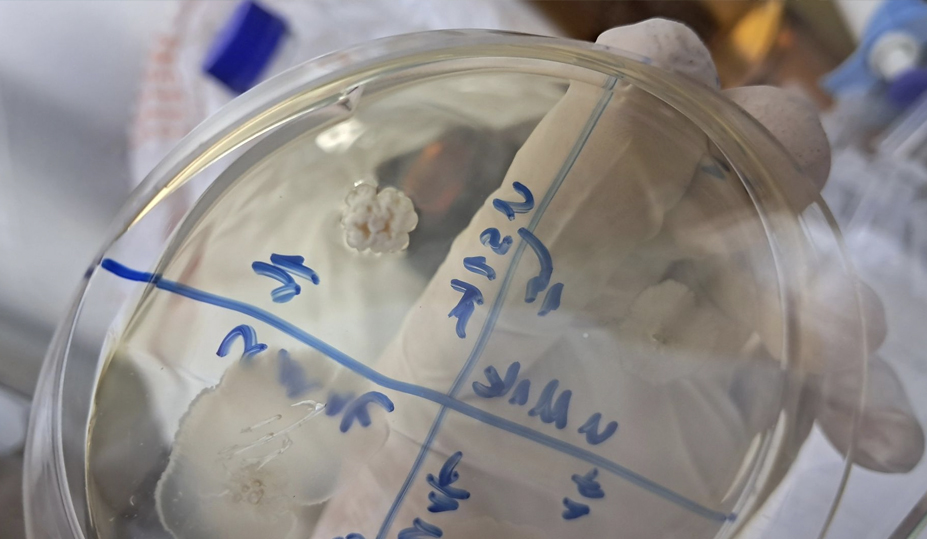

Toprak Biyoçeşitliliği Nedir?
Toprak Biyoçeşitliliği Nedir ve Neden Önemlidir? Toprak çoğu zaman yalnızca bitkilerin yetiştiği bir ortam olarak düşünülür. Oysa bir avuç toprağın içinde milyarlarca mikroorganizma ve çok sayıda farklı canlı türü bulunur. Bakteriler, mantarlar, protozoalar, nematodlar, böcekler ve daha birçok organizma birlikte çalışarak toprağın işleyişini belirleyen karmaşık bir yaşam ağı oluşturur. İşte bu çeşitlilik “toprak biyoçeşitliliği” olarak […]
Toprak Biyoçeşitliliği Nedir? Read More »